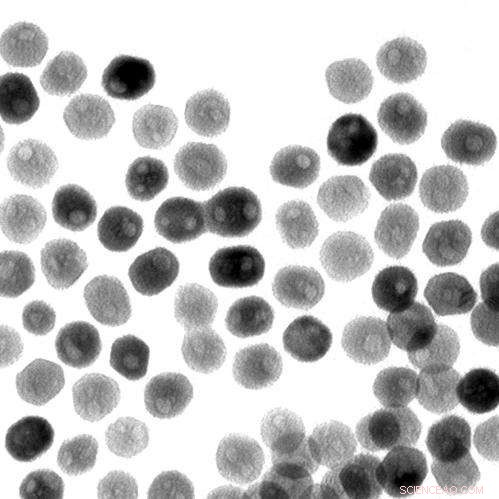
Nanoparticle Breakthrough Paves Way for Affordable Clean Energy

Cheaper clean-energy technologies could be made possible thanks to a new discovery. Research team members led by Raymond Schaak, a professor of chemistry at Penn State University, have found that an important chemical reaction that generates hydrogen from water is effectively triggered -- or catalyzed -- by a nanoparticle composed of nickel and phosphorus, two inexpensive elements that are abundant on Earth. This transmission-electron microscope image shows a collection of quasi-spherical nickel phosphide nanoparticles. Credit: Eric Popczun, Penn State University
(Phys.org) —Cheaper clean-energy technologies could be made possible thanks to a new discovery. Research team members led by Raymond Schaak, a professor of chemistry at Penn State University, have found that an important chemical reaction that generates hydrogen from water is effectively triggered—or catalyzed—by a nanoparticle composed of nickel and phosphorus, two inexpensive elements that are abundant on Earth. The results of the research will be published in the Journal of the American Chemical Society.
Schaak explained that the purpose of the nickel phosphide nanoparticle is to help produce hydrogen from water, which is a process that is important for many energy-production technologies, including fuel cells and solar cells. "Water is an ideal fuel, because it is cheap and abundant, but we need to be able to extract hydrogen from it," Schaak said. Hydrogen has a high energy density and is a great energy carrier, Schaak explained, but it requires energy to produce. To make its production practical, scientists have been hunting for a way to trigger the required chemical reactions with an inexpensive catalyst. Schaak noted that this feat is accomplished very well by platinum but, because platinum is expensive and relatively rare, he and his team have been searching for alternative materials. "There were some predictions that nickel phosphide might be a good candidate, and we had already been working with nickel phosphide nanoparticles for several years," Schaak said. "It turns out that nanoparticles of nickel phosphide are indeed active for producing hydrogen and are comparable to the best known alternatives to platinum."
To create the nickel phosphide nanoparticles, team members began with metal salts that are commercially available. They then dissolved these salts in solvents, added other chemical ingredients, and heated the solution to allow the nanoparticles to form. The researchers were able create a nanoparticle that was quasi-spherical—not a perfect sphere, but spherical with many flat, exposed edges. "The small size of the nanoparticles creates a high surface area, and the exposed edges means that a large number of sites are available to catalyze the chemical reaction that produces hydrogen," Schaak explained.

Cheaper clean-energy technologies could be made possible thanks to a new discovery. Research team members led by Raymond Schaak, a professor of chemistry at Penn State University, have found that an important chemical reaction that generates hydrogen from water is effectively triggered -- or catalyzed -- by a nanoparticle composed of nickel and phosphorus, two inexpensive elements that are abundant on Earth. This illustration shows hydrogen gas bubbling off of the surface of a nickel phosphide crystal. Credit: Eric Popczun, Penn State University
The next step was for team members at the California Institute of Technology to test the nanoparticles' performance in catalyzing the necessary chemical reactions. Led by Nathan S. Lewis, the George L. Argyros Professor of Chemistry at the California Institute of Technology, the researchers performed these tests by placing the nanoparticles onto a sheet of titanium foil and immersing that sheet in a solution of sulfuric acid. Next, the researchers applied a voltage and measured the current produced. They found that, not only were the chemical reactions happening as they had hoped, they also were happening with a high degree of efficacy.
"Nanoparticle technology has already started to open the door to cheaper and cleaner energy that is also efficient and useful," Schaak said. "The goal now is to further improve the performance of these nanoparticles and to understand what makes them function the way they do. Also, our team members believe that our success with nickel phosphide can pave the way toward the discovery of other new catalysts that also are comprised of Earth-abundant materials. Insights from this discovery may lead to even better catalysts in the future."